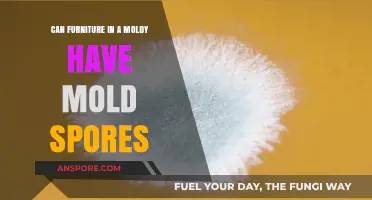
Moldy Furniture: Can It Harbor and Spread Mold Spores?

The question of whether fungal spores can survive in outer space is a fascinating intersection of biology and astrobiology, shedding light on the resilience of life in extreme environments. Fungal spores are known for their remarkable durability, capable of withstanding harsh conditions such as radiation, desiccation, and temperature extremes on Earth. However, the vacuum of space, intense cosmic radiation, and extreme temperature fluctuations present unique challenges that test the limits of their survival capabilities. Research, including experiments conducted on the International Space Station, has revealed that some fungal species, such as *Aspergillus* and *Cladosporium*, can endure exposure to space conditions for extended periods, raising intriguing possibilities about their role in interplanetary contamination and the potential for life to persist beyond Earth. Understanding this resilience not only advances our knowledge of fungal biology but also informs efforts to protect spacecraft from biological contamination and explore the boundaries of life's adaptability in the cosmos.
| Characteristics | Values |
|---|---|
| Survival in Space | Fungal spores can survive in outer space for extended periods, with some studies showing viability after exposure to space conditions for up to 18 months. |
| Resistance to Radiation | Fungal spores exhibit high resistance to ultraviolet (UV) radiation, galactic cosmic radiation, and solar particle events, due to their thick cell walls and DNA repair mechanisms. |
| Tolerance to Vacuum | Fungal spores can tolerate the vacuum of space, as they enter a dormant state that minimizes metabolic activity and water loss. |
| Temperature Extremes | Fungal spores can survive extreme temperatures, ranging from -20°C to 50°C, which are within the range experienced in low Earth orbit and on planetary surfaces. |
| Desiccation Tolerance | Fungal spores are highly tolerant to desiccation (drying), which is a critical factor for survival in the vacuum of space where water is scarce. |
| DNA Repair Mechanisms | Fungi possess efficient DNA repair mechanisms that enable them to recover from radiation-induced damage, enhancing their survival in space environments. |
| Species Variability | Different fungal species show varying levels of resistance to space conditions; for example, Aspergillus niger and Cladosporium sphaerospermum have demonstrated particularly high survival rates. |
| Potential for Panspermia | The resilience of fungal spores raises the possibility of panspermia, the hypothesis that life could be distributed throughout the universe via meteorites or spacecraft. |
| Experimental Evidence | Experiments conducted on the International Space Station (ISS) and during space missions have confirmed the survival of fungal spores in space conditions. |
| Implications for Astrobiology | The ability of fungal spores to survive in space has significant implications for astrobiology, including the potential for life to exist on other planets and the need for planetary protection measures. |
Explore related products
What You'll Learn
- Fungal spore resistance to radiation exposure in space environments
- Effects of microgravity on fungal spore viability and growth
- Survival of fungal spores in extreme space temperature fluctuations
- Role of fungal spore cell wall structure in space survival
- Potential for fungal spores to contaminate extraterrestrial habitats

Fungal spore resistance to radiation exposure in space environments
Fungal spores exhibit remarkable resilience to extreme conditions, including the harsh radiation environment of outer space. Studies have shown that certain fungal species, such as *Aspergillus* and *Cladosporium*, can withstand exposure to ultraviolet (UV) radiation, gamma rays, and even the vacuum of space. For instance, experiments conducted on the International Space Station (ISS) exposed fungal spores to doses of up to 500 Gy of gamma radiation, a level that would be lethal to most organisms. Despite this, a significant portion of the spores remained viable, demonstrating their extraordinary resistance.
To understand this resistance, consider the protective mechanisms fungi employ. Fungal spores possess thick cell walls composed of chitin and melanin, which act as natural shields against radiation. Melanin, in particular, is highly effective at absorbing and dissipating radiation energy, reducing damage to the spore’s DNA. Additionally, spores enter a dormant state, minimizing metabolic activity and further enhancing their survival capabilities. These adaptations make fungi ideal candidates for studying extremophile biology and potential applications in astrobiology.
For researchers and space agencies, understanding fungal spore resistance has practical implications. Fungal contamination poses a risk to spacecraft and space habitats, as spores can survive long-term missions and potentially compromise equipment or astronaut health. To mitigate this, sterilization protocols must account for fungal hardiness. Methods such as heat treatment (e.g., 121°C for 15 minutes) or chemical disinfectants like hydrogen peroxide are effective but must be rigorously applied. Monitoring fungal presence in closed environments, such as the ISS, is also critical to prevent outbreaks.
Comparatively, fungal spores outperform many bacterial and viral counterparts in radiation resistance. While bacterial endospores, like those of *Bacillus subtilis*, are highly resilient, fungal spores often surpass them in durability. For example, *Cryptococcus neoformans* spores have been shown to survive doses of UV radiation that would inactivate most bacteria. This comparative advantage highlights the unique evolutionary strategies fungi have developed to endure extreme environments, both on Earth and in space.
In conclusion, fungal spore resistance to radiation exposure in space environments is a testament to their evolutionary adaptability. Their thick cell walls, melanin pigmentation, and dormancy mechanisms enable survival under conditions that would destroy most life forms. For space exploration, this resilience necessitates robust sterilization and monitoring practices to prevent fungal contamination. As we continue to explore the cosmos, studying these extremophiles not only advances astrobiology but also informs strategies for protecting human missions and equipment from microbial threats.
Are Spore Syringes Legal in the UK? A Comprehensive Guide
You may want to see also

Effects of microgravity on fungal spore viability and growth
Fungal spores, renowned for their resilience on Earth, face a unique challenge in the microgravity environment of outer space. This condition, characterized by near weightlessness, significantly alters biological processes, raising questions about spore viability and growth.
Microgravity disrupts cellular processes fundamental to fungal survival. Fluid dynamics within cells change, potentially hindering nutrient uptake and waste removal. This can lead to metabolic imbalances and reduced energy production, crucial for spore germination and growth. Additionally, microgravity can induce stress responses in fungi, triggering the production of reactive oxygen species (ROS) which, if unchecked, can damage cellular components and compromise viability.
Studies have shown that microgravity can indeed impact fungal spore viability. Experiments conducted on the International Space Station (ISS) revealed that while some fungal species, like *Aspergillus niger*, exhibited reduced germination rates, others, such as *Trichoderma harzianum*, showed increased spore production. These contrasting results highlight the species-specific nature of fungal responses to microgravity.
Understanding these variations is crucial for several reasons. Firstly, it aids in predicting the behavior of fungi in space environments, both within spacecraft and on potential extraterrestrial habitats. Secondly, it provides insights into fundamental fungal biology, shedding light on the mechanisms underlying spore dormancy, germination, and stress adaptation.
To further investigate the effects of microgravity, researchers employ various techniques. Ground-based simulations using clinostats, which rotate samples to create a microgravity-like environment, offer a cost-effective approach. However, true microgravity conditions can only be achieved in space-based experiments, often utilizing specialized hardware on the ISS. These experiments typically involve exposing fungal spores to microgravity for defined periods, followed by analysis of germination rates, metabolic activity, and gene expression changes upon return to Earth.
By combining these approaches, scientists are gradually unraveling the complex interplay between microgravity and fungal spore biology. This knowledge not only advances our understanding of life in extreme environments but also has practical applications in fields like space exploration, biotechnology, and even agriculture.
Are Liquid Culture Spores Legal? Understanding the Legal Landscape
You may want to see also

Survival of fungal spores in extreme space temperature fluctuations
Fungal spores are remarkably resilient, capable of withstanding conditions that would destroy most life forms. However, the extreme temperature fluctuations in outer space, ranging from near-absolute zero in shadowed areas to hundreds of degrees Celsius in direct sunlight, pose a unique challenge. These rapid shifts, often occurring within minutes, test the limits of even the hardiest spores. Understanding their survival mechanisms in such environments is crucial for both astrobiology and planetary protection efforts.
To assess survival, consider the spore’s protective structures. Fungal spores, such as those from *Aspergillus* or *Cryptococcus*, possess thick cell walls composed of chitin and melanin, which act as natural shields against radiation and desiccation. Melanin, in particular, absorbs UV radiation and stabilizes cellular structures, potentially mitigating temperature-induced damage. However, extreme cold can slow metabolic processes to a halt, while rapid heating may denature proteins and disrupt membranes. Experiments simulating space conditions have shown that spores can survive temperatures as low as -20°C and as high as 100°C for short durations, but prolonged exposure to these extremes reduces viability significantly.
A comparative analysis reveals that fungal spores outperform bacterial endospores in certain space-like conditions. For instance, *Aspergillus niger* spores exposed to vacuum and UV radiation retained higher germination rates compared to *Bacillus subtilis* endospores. This suggests that fungal spores’ thicker cell walls and melanin content provide superior protection against temperature shocks. However, the lack of an atmosphere in space exacerbates desiccation, which, combined with temperature fluctuations, creates a synergistic threat. Hydration levels prior to exposure play a critical role; spores with higher water content are more susceptible to freeze-thaw damage, while desiccated spores fare better in extreme cold.
Practical implications of this resilience are significant for space exploration. Fungal spores could inadvertently contaminate extraterrestrial environments via spacecraft, compromising astrobiological research. To mitigate this, sterilization protocols must account for their hardiness. For example, NASA’s planetary protection guidelines recommend dry heat sterilization at 114°C for 40 hours, which effectively inactivates most fungal spores. However, emerging technologies like hydrogen peroxide vapor or UV-C radiation offer faster, more energy-efficient alternatives. For researchers handling samples in space or simulating space conditions, maintaining strict containment protocols and monitoring spore viability post-exposure are essential steps to prevent unintended contamination.
In conclusion, while fungal spores exhibit impressive tolerance to extreme temperatures, their survival in space is not indefinite. The interplay of desiccation, radiation, and temperature fluctuations ultimately limits their longevity. By studying these mechanisms, we not only advance our understanding of life’s boundaries but also ensure the integrity of space missions and the preservation of pristine extraterrestrial environments.
Bacillus Anthracis Spores: Understanding Their Role in Anthrax Infections
You may want to see also
Explore related products

Role of fungal spore cell wall structure in space survival
Fungal spores possess a remarkably resilient cell wall structure, a feature that has sparked curiosity about their potential to endure the harsh conditions of outer space. This intricate architecture, primarily composed of chitin, glucans, and proteins, forms a robust barrier against environmental stressors. Unlike bacterial cell walls, which are more susceptible to desiccation and radiation, fungal cell walls exhibit a layered complexity that may contribute to their survival in extreme environments. The outer layer, rich in melanin, acts as a protective shield, absorbing harmful UV radiation and preventing DNA damage. This unique composition raises the question: could the fungal spore's cell wall be the key to its extraterrestrial resilience?
Consider the process of desiccation tolerance, a critical factor in space survival. Fungal spores enter a state of dormancy when dehydrated, slowing metabolic processes to a near halt. The cell wall plays a pivotal role in this mechanism by maintaining structural integrity and preventing membrane damage. For instance, the presence of chitin, a rigid polysaccharide, provides a sturdy framework that resists collapse under vacuum conditions. Additionally, the cell wall's ability to bind water molecules in a semi-crystalline state allows spores to retain minimal moisture, essential for reviving metabolic functions upon rehydration. This adaptive strategy is not just theoretical; experiments have shown that fungal spores can survive in a vacuum for extended periods, with some species enduring up to 24 hours without significant viability loss.
To understand the practical implications, let’s examine a comparative study between *Aspergillus niger* and *Saccharomyces cerevisiae*. The former, with its thicker cell wall and higher melanin content, demonstrated greater resistance to UV radiation and temperature fluctuations compared to the latter. This highlights the importance of cell wall thickness and composition in space survival. For researchers designing experiments, exposing spores to gradual desiccation and UV radiation in a controlled environment can simulate space conditions. A recommended protocol involves dehydrating spores to 10% moisture content, followed by exposure to 254 nm UV light for 2 hours, and monitoring viability using a tetrazolium-based assay.
However, the cell wall’s role is not without limitations. While it provides structural protection, prolonged exposure to cosmic radiation and extreme temperatures can still compromise spore integrity. For instance, doses exceeding 1000 Gy of ionizing radiation have been shown to significantly reduce spore viability, even in highly resistant species like *Cryptococcus neoformans*. To mitigate this, incorporating radioprotective compounds like trehalose or glycerol into experimental setups can enhance survival rates. These compounds stabilize cell wall structures and prevent protein denaturation, offering a practical solution for future space missions aiming to transport fungal spores.
In conclusion, the fungal spore’s cell wall structure is a marvel of evolutionary adaptation, offering a natural defense against the rigors of outer space. Its layered composition, desiccation tolerance, and radiation-absorbing properties make it a subject of immense scientific interest. By studying these mechanisms, researchers can not only answer the question of space survival but also harness this knowledge for applications in astrobiology, biotechnology, and even food preservation in space. The next step? Developing synthetic cell wall mimics that could protect other microorganisms or even human cells in extraterrestrial environments.
Moss Spores vs. Sporangium: Unraveling the Tiny Reproductive Structures
You may want to see also

Potential for fungal spores to contaminate extraterrestrial habitats
Fungal spores are remarkably resilient, capable of withstanding extreme conditions on Earth, from arid deserts to radioactive environments. This hardiness raises a critical concern for space exploration: could these spores survive the harsh conditions of outer space and potentially contaminate extraterrestrial habitats? Understanding this risk is essential as we establish long-term human presence on the Moon, Mars, or beyond.
Consider the journey of fungal spores in space. Exposed to vacuum, extreme temperatures, and unfiltered solar radiation, they face challenges far beyond terrestrial extremes. Yet, studies like those conducted by the European Space Agency (ESA) have shown that certain fungal species, such as *Aspergillus niger* and *Cladosporium sphaerospermum*, can survive in space-like conditions for extended periods. For instance, spores exposed to Mars-like conditions in simulations retained viability after 14 days, despite UV radiation doses exceeding 2000 J/m²—far higher than what typically inactivates most microorganisms.
The implications of such resilience are profound. Fungal contamination of extraterrestrial habitats could compromise life support systems, damage equipment, or even pose health risks to astronauts. For example, mold growth in closed environments like the International Space Station (ISS) has already been documented, highlighting the potential for spores to thrive in microgravity. If unchecked, these spores could establish colonies in lunar or Martian bases, leveraging the very habitats designed to sustain human life.
Mitigating this risk requires proactive measures. Sterilization protocols for spacecraft and equipment must be rigorously enforced, using methods like dry heat sterilization or chemical disinfectants. Additionally, monitoring systems should be integrated into habitats to detect early signs of fungal growth. For astronauts, personal protective equipment and hygiene practices must be adapted to minimize spore dispersal. Finally, research into antifungal materials and coatings could provide long-term solutions for habitat construction.
In conclusion, the potential for fungal spores to contaminate extraterrestrial habitats is a tangible threat, but not an insurmountable one. By leveraging existing knowledge of fungal resilience and implementing targeted strategies, we can safeguard future space missions and ensure the integrity of off-Earth environments. The challenge lies not in eliminating all risk, but in managing it effectively to support sustainable human exploration.
Can Spores Produce Toxins? Unveiling the Hidden Dangers of Microbial Spores
You may want to see also
Frequently asked questions
Yes, fungal spores have demonstrated remarkable resilience and can survive in the extreme conditions of outer space, including vacuum, radiation, and temperature fluctuations.
Studies suggest fungal spores can remain viable for extended periods in space, potentially years, depending on factors like radiation exposure and temperature.
Fungal spores could potentially contaminate other planets or spacecraft, though strict planetary protection protocols are in place to minimize this risk.
Extremophilic fungi, such as *Aspergillus* and *Cladosporium*, are more likely to survive due to their ability to withstand harsh environments.
Fungal spores have thick cell walls and can enter a dormant state, which helps them withstand extreme conditions like radiation, vacuum, and desiccation.





![Don't Die In The Woods - Freakin’ Huge Emergency Blankets [4-Pack] Extra Large Thermal Mylar Space Blanket - One of The Ten Essentials Outdoor Survival Gear for Hiking Camping First Aid Kit (Orange)](https://m.media-amazon.com/images/I/81qzkfD+Y0L._AC_UY218_.jpg)

![Don't Die In The Woods - Freakin’ Huge Emergency Blankets [4-Pack] Extra Large Thermal Mylar Space Blanket - One of The Ten Essentials Outdoor Survival Gear for Hiking Camping First Aid Kit (Green)](https://m.media-amazon.com/images/I/81t18xyG+aL._AC_UY218_.jpg)